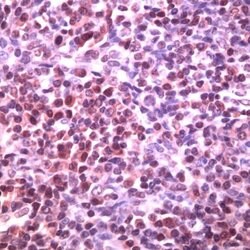

Learn More
BCL6 Rabbit anti-Human, Polyclonal, Invitrogen™
Rabbit Polyclonal Antibody
Supplier: Thermo Scientific PA532273
Description
Heat-mediated antigen retrieval is recommended prior to staining, using a 10mM citrate buffer, pH 6.0, for 10 minutes followed by cooling at room temperature for 20 min. Following antigen retrieval, incubate samples with primary antibody for 30 min at room temperature. A suggested positive control is tonsil tissue.
BCL-6 proto-oncogene product (a Kruppel-type zinc-finger protein) is mainly expressed in normal germinal center B cells and related lymphomas. BCL-6 is involved in chromosome rearrangements at 3q27 in non-Hodgkin′s lymphomas and BCL-6 rearrangements have been detected in 33%-45% of diffuse large B cell lymphomas. Bcl-6 has been detected immunohistochemically in follicular lymphomas, diffuse large B cell lymphomas, Burkitt′s lymphomas and in nodular, lymphocyte predomit Hodgkin′s disease.
Specifications
| BCL6 | |
| Polyclonal | |
| BCL6 | |
| BCL5, BCL6A, LAZ3, ZBTB27, ZNF51, B-cell lymphoma 5 protein, B-cell lymphoma 6 protein, B-cell lymphoma 6 protein transcript, BCL-5, BCL-6, cys-his2 zinc finger transcription factor, lymphoma-associated zinc finger gene on chromosome 3, protein LAZ-3, zinc finger and BTB domain-containing protein | |
| Rabbit | |
| Antigen affinity chromatography | |
| RUO | |
| 604 | |
| Store at 4°C short term. For long term storage, store at -20°C, avoiding freeze/thaw cycles. | |
| Liquid |
| Immunohistochemistry (Paraffin), Western Blot | |
| Unconjugated | |
| P41182 | |
| BCL6 | |
| Synthetic peptide corresponding to internal region of human BCL-6 protein. | |
| 500 μL | |
| Primary | |
| Human | |
| Antibody | |
| IgG |
Your input is important to us. Please complete this form to provide feedback related to the content on this product.